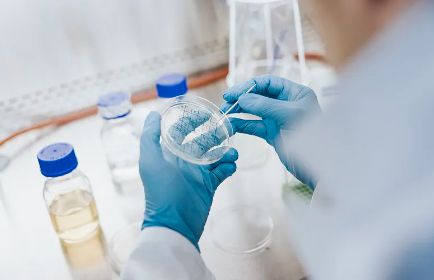
image.png

干細(xì)胞療法最新資訊有哪些?治愈案例分享?
2024-10-25 14:31:26 來(lái)源: 小編 咨詢(xún)醫(yī)生
一、干細(xì)胞療法最新資訊
近年來(lái),干細(xì)胞療法在醫(yī)學(xué)領(lǐng)域取得了顯著的進(jìn)展。以下是一些關(guān)于干細(xì)胞療法的最新資訊:
1.技術(shù)突破:科學(xué)家們已經(jīng)成功研發(fā)出一種新型干細(xì)胞培養(yǎng)技術(shù),使得干細(xì)胞來(lái)源更加豐富、純度更高,為臨床應(yīng)用提供了更好的基礎(chǔ)。
2.**支持:我國(guó)**高度重視干細(xì)胞療法的研究與應(yīng)用,出臺(tái)了一系列**鼓勵(lì)和支持干細(xì)胞療法的發(fā)展,為研究者提供了良好的**環(huán)境。
3.國(guó)際合作:我國(guó)與國(guó)際上的科研團(tuán)隊(duì)在干細(xì)胞療法領(lǐng)域開(kāi)展了廣泛的合作,共同推動(dòng)這一領(lǐng)域的研究與發(fā)展。
4.臨床試驗(yàn):目前,全球范圍內(nèi)已有多個(gè)干細(xì)胞療法臨床試驗(yàn)開(kāi)展,涵蓋了神經(jīng)系統(tǒng)疾病、心血管疾病、免疫系統(tǒng)疾病等多個(gè)領(lǐng)域。
二、治愈案例分享
以下是幾個(gè)干細(xì)胞療法成功治愈的案例:
1.帕金森?。阂幻?0歲的帕金森病患者在接受干細(xì)胞療法后,病情得到了顯著改善。經(jīng)過(guò)一段時(shí)間的治療,患者運(yùn)動(dòng)能力提高,顫抖現(xiàn)象減少,生活質(zhì)量得到了明顯提升。
2.心肌梗死:一名40歲的心肌梗死患者,在采用干細(xì)胞療法后,心臟功能得到了明顯恢復(fù)。經(jīng)過(guò)多次治療,患者心梗面積縮小,心功能逐漸恢復(fù)正常。
3.脊髓損傷:一名22歲的脊髓損傷患者,在采用干細(xì)胞療法后,下肢運(yùn)動(dòng)功能得到了恢復(fù)。經(jīng)過(guò)一段時(shí)間的康復(fù)訓(xùn)練,患者已能**行走。
4.類(lèi)風(fēng)濕性關(guān)節(jié)炎:一名30歲的類(lèi)風(fēng)濕性關(guān)節(jié)炎患者,在采用干細(xì)胞療法后,關(guān)節(jié)疼痛減輕,活動(dòng)能力提高。經(jīng)過(guò)治療,患者生活質(zhì)量得到了很大改善。
三、總結(jié)
干細(xì)胞療法作為一種前沿生物技術(shù),在眾多疾病的治療中取得了顯著的成果。隨著科研技術(shù)的不斷發(fā)展,相信在未來(lái),干細(xì)胞療法將為更多患者帶來(lái)希望,助力人類(lèi)邁向健康長(zhǎng)壽。同時(shí),我們也應(yīng)關(guān)注干細(xì)胞療法的倫理問(wèn)題,確保其在合規(guī)、安全的前提下為人類(lèi)造福。
- 2024-10-28干細(xì)胞治療胃病的費(fèi)用大概多少?
- 2024-11-28干細(xì)胞療法應(yīng)用領(lǐng)域有哪些,與傳統(tǒng)療法相比有何優(yōu)勢(shì)
- 2024-08-12干細(xì)胞治療視網(wǎng)膜色素變性的原理
- 2024-11-06干細(xì)胞嫁接治療腦癱效果顯著嗎?
- 2024-11-25干細(xì)胞再生療法的缺點(diǎn)是什么,如何規(guī)避這些風(fēng)險(xiǎn)
- 2024-09-02干細(xì)胞治療成功治愈率高嗎,干細(xì)胞治療疾病徹底嗎
- 2024-09-15人參干細(xì)胞的作用和功效,人參植物干細(xì)胞的用途
- 2024-08-07干細(xì)胞療法治療肝硬化,干細(xì)胞治療肝硬化有效果嗎
- 2024-09-04博雅干細(xì)胞存儲(chǔ)多少錢(qián)一年,博雅干細(xì)胞收費(fèi)標(biāo)準(zhǔn)
- 2024-07-19干細(xì)胞祛皺,干細(xì)胞祛皺效果好嗎
- 2024-09-22深圳儲(chǔ)存干細(xì)胞費(fèi)用,一文全面解析
- 2024-09-07造血干細(xì)胞二次回輸?shù)淖饔?,什么是干?xì)胞回輸
- 2024-09-24干細(xì)胞能治什么病?干細(xì)胞具有什么能力
- 2024-08-06打一針干細(xì)胞要多少錢(qián),打一針干細(xì)胞能管幾年
- 2024-09-28干細(xì)胞抗衰老最新指南,如何科學(xué)抗衰老
- 2024-09-27貝拉國(guó)際醫(yī)療中心是正規(guī)醫(yī)院?jiǎn)?/a>
- 2024-09-12耳聾干細(xì)胞治療如何,附方法原理介紹
- 2024-09-02甲狀腺干細(xì)胞再生療法有哪些
